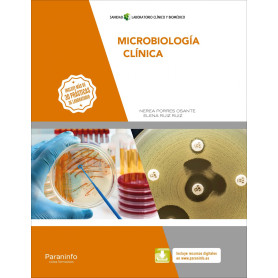
MICROBIOLOGÍA CLÍNICA  JEYJO

9788468214702 EP 5 - MATEMATICAS CUAD - AULA ACTIVA VICENS (T25)
LIBROS TEXTO
Hay 19191 productos.
9788428339445 OPERACIONES ADMINISTRATIVAS DE COMPRAVENTA CICLOS FORMATIVOS
Sin Stock
OPERACIONES ADMINISTRATIVAS DE COMPRAVENTA Autor: Ayensa Esparza, Ángel María
41,91 €
9788428339452 GESTIÓN DE LA DOCUMENTACIÓN JURÍDICA Y EMPRESARIAL CICLOS FORMATIVOS
Sin Stock
GESTIÓN DE LA DOCUMENTACIÓN JURÍDICA Y EMPRESARIAL Autor: Bahillo Marcos, M.E.;Perez Bravo, M.C.
43,26 €
9788428339469 OPERACIONES AUXILIARES DE GESTIÓN DE TESORERÍA CICLOS FORMATIVOS
Sin Stock
OPERACIONES AUXILIARES DE GESTIÓN DE TESORERÍA Autor: Bahíllo, M.ª Eugenia;Pérez, M.ªCarmen
41,91 €
9788428339476 SERVICIOS DE ATENCIÓN COMERCIAL CICLOS FORMATIVOS
Sin Stock
SERVICIOS DE ATENCIÓN COMERCIAL Autor: Carrasco Fernández, Soledad
28,00 €
9788428339483 Atención al cliente, consumidor y usuario CICLOS FORMATIVOS
Sin Stock
Atención al cliente, consumidor y usuario Autor: LÓPEZ SALAS, SERGIO
31,50 €
9788428339629 RECURSOS TURÍSTICOS CICLOS FORMATIVOS
Sin Stock
RECURSOS TURÍSTICOS Autor: Rojo Gil, Rocío/Martínez Leal, Beatriz
29,00 €
9788428339643 TRATAMIENTO Y RECUBRIMIENTO DE SUPERFICIES CICLOS FORMATIVOS
Sin Stock
TRATAMIENTO Y RECUBRIMIENTO DE SUPERFICIES Autor: VV.AA.
44,00 €
9788428339681 AU SERVICE DU CLIENT CICLOS FORMATIVOS
Sin Stock
AU SERVICE DU CLIENT Autor: Mota Iglesias, Arantxa
35,00 €
9788428339711 CULTURA AUDIOVISUAL II 2 BACHILLERATO
Sin Stock
CULTURA AUDIOVISUAL II Autor: Castillo, José María
25,69 €
9788428339780 ORGANIZACIÓN DEL SERVICIO DE INFORMACIÓN TURÍSTICA LOCAL CICLOS FORMATIVOS
Sin Stock
ORGANIZACIÓN DEL SERVICIO DE INFORMACIÓN TURÍSTICA LOCAL Autor: Jesús Garrido, Silvia
0,00 €
9788428339834 ELABORACIÓN Y EXPOSICIÓN DE COMIDAS EN EL BAR-CAFETERÍA CICLOS FORMATIVOS
Sin Stock
ELABORACIÓN Y EXPOSICIÓN DE COMIDAS EN EL BAR-CAFETERÍA Autor: Motto López, Marina;Fernández, Miguel Ángel
0,00 €
9788428339841 MONTAJE Y MANTENIMIENTO DE SISTEMAS Y COMPONENTES INFORMÁTICOS 2019 F.P.BASICA
Sin Stock
MONTAJE Y MANTENIMIENTO DE SISTEMAS Y COMPONENTES INFORMÁTICOS 2019 Autor: Berral Montero, Isidoro
28,50 €
9788428339926 Comercialización de productos y servicios turísticos locales CICLOS FORMATIVOS
Sin Stock
Comercialización de productos y servicios turísticos locales Autor: Fernández Villarán, Ana Asunción
0,00 €
9788428340007 SISTEMA DE INFORMACIÓN DE MERCADOS CICLOS FORMATIVOS
Sin Stock
SISTEMA DE INFORMACIÓN DE MERCADOS Autor: Martínez Valverde, José Fulgencia
28,00 €
9788428340069 GESTIÓN DEL MONTAJE Y DEL MANTENIMIENTO DE INSTALACIONES ELECTRICAS 2018 CICLOS FORMATIVOS
Sin Stock
GESTIÓN DEL MONTAJE Y DEL MANTENIMIENTO DE INSTALACIONES ELECTRICAS 2018 Autor: Morales Santiago, Gregorio
28,00 €
9788428340083 Mecanizado básico para electromecánica 2.ª edición 2023 CICLOS FORMATIVOS
Sin Stock
Mecanizado básico para electromecánica 2.ª edición 2023 Autor: ÁGUEDA CASADO, EDUARDO
35,00 €
9788428340090 SISTEMAS DE TRANSMISIÓN Y FRENADO 2019 CICLOS FORMATIVOS
Sin Stock
SISTEMAS DE TRANSMISIÓN Y FRENADO 2019 Autor: VV.AA.
35,00 €
9788428340113 INSTALACIONES SOLARES FOTOVOLTAICAS (2ªED. ACTUALIZADA) CICLOS FORMATIVOS
Sin Stock
INSTALACIONES SOLARES FOTOVOLTAICAS (2ªED. ACTUALIZADA) Autor: Moro Vallina, Miguel
36,00 €
9788428340137 Comercialización de eventos CICLOS FORMATIVOS
Sin Stock
Comercialización de eventos Autor: SALESA AMARANTE, NURIA
24,00 €
9788428340182 PROTOCOLO EMPRESARIA. GRADO SUPERIOR CICLOS FORMATIVOS
Sin Stock
PROTOCOLO EMPRESARIA. GRADO SUPERIOR Autor:
30,00 €
9788428340212 TÉCNICAS Y PROCESOS EN INFRAESTRUCTURAS DE TELECOMUNICACIONES CICLOS FORMATIVOS
Sin Stock
TÉCNICAS Y PROCESOS EN INFRAESTRUCTURAS DE TELECOMUNICACIONES Autor: Millán Esteller, Juan M.
44,62 €
9788428340236 FINANCIACIÓN INTERNACIONAL 2019 CICLOS FORMATIVOS
Sin Stock
FINANCIACIÓN INTERNACIONAL 2019 Autor: Rodes, Adolf
29,74 €
9788428340267 MICROBIOLOGÍA CLÍNICA CICLOS FORMATIVOS
Sin Stock
MICROBIOLOGÍA CLÍNICA Autor: Porres Osante, Nerea;Ruiz Ruiz, Elena
32,00 €
9788428340403 NEGOCIACIÓN INTERNACIONAL. GRADO SUPERIOR CICLOS FORMATIVOS
Sin Stock
NEGOCIACIÓN INTERNACIONAL. GRADO SUPERIOR Autor:
33,80 €
9788428340434 INSTALACIONES DE TELECOMUNICACIONES F.P.BASICA
Sin Stock
INSTALACIONES DE TELECOMUNICACIONES Autor: Hidalgo Iturralde, Tomás Cerdá Filiu, Luis Miguel
22,00 €
9788428340557 SISTEMAS DE MEDIDA Y REGULACIÓN CICLOS FORMATIVOS
Sin Stock
SISTEMAS DE MEDIDA Y REGULACIÓN Autor: Escaño Gonzalez, Juan Manuel
28,00 €
9788428340656 DETERMINACIÓN DEL ESTADO SANITARIO DE LAS PLANTAS, SUELO E INSTALACIONES Y ELEC CICLOS FORMATIVOS
Sin Stock
DETERMINACIÓN DEL ESTADO SANITARIO DE LAS PLANTAS, SUELO E INSTALACIONES Y ELECCIÓN DE MÉTODOS DE CONTROL Autor: Soria Carreras, Santiago
0,00 €
33,00 €
9788428340854 RECEPCIÓN Y RESERVAS CICLOS FORMATIVOS
Sin Stock
RECEPCIÓN Y RESERVAS Autor: Rodríguez Del Río, María Estela
29,00 €
9788428340885 Mediación comunitaria CICLOS FORMATIVOS
Sin Stock
Mediación comunitaria Autor: VIQUEIRA GARCÍA, VANESSA
29,00 €
9788428340892 TEORÍA Y PRÁCTICA DE LA CALIDAD UNIVERSIDAD
Sin Stock
TEORÍA Y PRÁCTICA DE LA CALIDAD Autor: Sanguesa, Marta;Mateo, Ricardo;Ilzarbe, Laura
0,00 €
9788428340908 Operaciones básicas de fabricación F.P.BASICA
Sin Stock
Operaciones básicas de fabricación Autor: MATO SAN JOSÉ, MIGUEL ÁNGEL
26,50 €
9788428340915 POSTRES EN RESTAURACIÓN CICLOS FORMATIVOS
Sin Stock
POSTRES EN RESTAURACIÓN Autor: Domenech, Raquel;Such, Alejandro Luis Mateo, Carla
30,00 €
9788428340946 ELABORACIONES DE PASTELERÍA Y REPOSTERÍA EN COCINA CICLOS FORMATIVOS
Sin Stock
ELABORACIONES DE PASTELERÍA Y REPOSTERÍA EN COCINA Autor: Carrero, Pilar;Armendariz, José Luis
32,00 €
9788428340977 CIRCUITOS DE FLUIDOS. SUSPENSIÓN Y DIRECCIÓN 2018 CICLOS FORMATIVOS
Sin Stock
CIRCUITOS DE FLUIDOS. SUSPENSIÓN Y DIRECCIÓN 2018 Autor: Pérez Bello, Miguel Ángel
43,26 €
9788428340984 GESTIÓN ADMINISTRATIVA Y COMERCIAL EN RESTAURACIÓN CICLOS FORMATIVOS
Sin Stock
GESTIÓN ADMINISTRATIVA Y COMERCIAL EN RESTAURACIÓN Autor: Díaz Paniagua, Elena;León Sánchez, Miriam
33,00 €
9788428340991 RECURSOS HUMANOS Y DIRECCIÓN DE EQUIPOS EN RESTAURACIÓN. GRADO SUPERIOR. CICLOS CICLOS FORMATIVOS
Sin Stock
RECURSOS HUMANOS Y DIRECCIÓN DE EQUIPOS EN RESTAURACIÓN. GRADO SUPERIOR. CICLOS FORMATIVOS Autor:
29,00 €
9788428341004 SISTEMAS DE POTENCIA CICLOS FORMATIVOS
Sin Stock
SISTEMAS DE POTENCIA Autor: ESCAÑO GONZALEZ JUAN MANUEL
31,00 €
9788428341011 TÉCNICAS Y PROCESOS EN INSTALACIONES DOMÓTICAS Y AUTOMÁTICAS CICLOS FORMATIVOS
Sin Stock
TÉCNICAS Y PROCESOS EN INSTALACIONES DOMÓTICAS Y AUTOMÁTICAS Autor: Gallardo Vázquez, Sergio
29,00 €
9788428341028 CONFIGURACIÓN DE INSTALACIONES DOMÓTICAS Y AUTOMÁTICAS. GRADO SUPERIOR. CICLOS CICLOS FORMATIVOS
Sin Stock
CONFIGURACIÓN DE INSTALACIONES DOMÓTICAS Y AUTOMÁTICAS. GRADO SUPERIOR. CICLOS FORMATIVOS Autor:
33,00 €
9788428341035 Gestión del departamento de pisos CICLOS FORMATIVOS
Sin Stock
Gestión del departamento de pisos Autor: RODRÍGUEZ DEL RIO, Mª ESTELA
32,00 €
9788428341066 GESTIÓN AVANZADA DE LA INFORMACIÓN CICLOS FORMATIVOS
Sin Stock
GESTIÓN AVANZADA DE LA INFORMACIÓN Autor: Valladares Vela, Mario
29,00 €